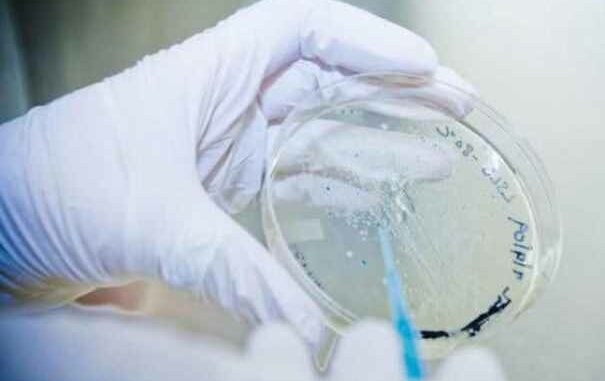

Le bilan d’une mystérieuse maladie dans un village du centre de la Côte d’Ivoire s’est alourdi lundi, passant de 7 à 9 morts après le décès de deux autres enfants, a appris mardi l’AFP auprès de villageois et de source hospitalière.
Selon Toungbo Yao, un habitant du village de Nianghan proche de Bouaké, « deux autres enfants sont décédés lundi », ce qu’a confirmé une source hospitalière médicale, ajoutant que sur les 59 personnes hospitalisées depuis dimanche au CHU de Bouaké, « cinquante sont rentrées au village ».
« Actuellement, tous les prélèvements sont au laboratoire et nous n’avons pas encore les résultats, donc les origines » de la maladie mortelle « ne sont pas encore connues », a ajouté cette source sous couvert d’anonymat.
Une autre source à l’hôpital a confirmé que toutes les personnes hospitalisées et les enfants décédés avaient consommé le même aliment, de la bouillie de maïs.
« Nous sommes tous abattus par ce grand malheur qui frappe notre village », a déclaré un autre de ses habitants, Raymond Koffi.
En février, dans le village de Kpo-Kahankro, également proche de Bouaké, deux personnes avaient été condamnées à cinq ans de prison après une contamination au clostridium, bactérie qui avait fait 16 morts selon un bilan officiel, 21 selon les villageois.
SOURCE : AFP







